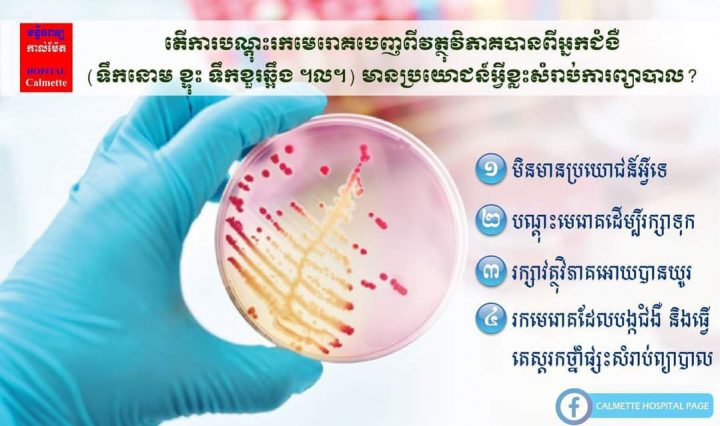

កីឡាបាល់ទះកម្ពុជា តស៊ូលើទីលានប្រកួត រហូតដល់រកបានពិន្ទុ វគ្គផ្តាច់ព្រាត់ !
ភ្នំពេញ : ប្រជាពលរដ្ឋខ្មែរ រាប់ម៉ឺន រាប់លាននាក់ បង្ហាញនូវអារម្មណ៍អស់ក្តីសង្ឃឹមយ៉ាងខ្លាំង បន្ទាប់ពីកីឡាបាល់ទះកម្ពុជា ប្រកួតចាញ់ផ្ទួនៗពីសិ៊តដំបូងពី កីឡាបាល់ទះថៃ ! … អានបន្ថែម កីឡាបាល់ទះកម្ពុជា តស៊ូលើទីលានប្រកួត រហូតដល់រកបានពិន្ទុ វគ្គផ្តាច់ព្រាត់ !